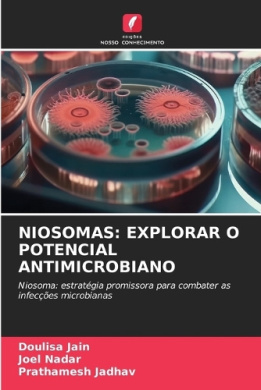
https://raw.githubusercontent.com/stevesteve2020-lab/img/refs/heads/main/quWQUKa7wRR7YT.jpeg

-
-90%

Nanotubes de carbone parois multiples portant de l’artsunate pour le paludisme crbral
0Original price was: $116.00.$12.00Current price is: $12.00.Nanotubes de carbone parois multiples portant de l’artsunate pour le paludisme crbral, , 9786203682700
-
-57%

Neue Technologien in Der Arzneimittelforschung: Von AI Bis Crispr
0Original price was: $42.00.$18.00Current price is: $18.00.Neue Technologien in Der Arzneimittelforschung: Von AI Bis Crispr, , 9786208339425
-
-90%

Neuroradiologie interventionnelle: valuation conomique
0Original price was: $98.00.$10.00Current price is: $10.00.Neuroradiologie interventionnelle: valuation conomique, , 9786206719205
-
-72%

Newborn Surgery, Fourth Edition
0Original price was: $57.00.$16.00Current price is: $16.00.Newborn Surgery, Fourth Edition, Parashis, Andreas, 9781482247701
-
-86%
Niosomas: Explorar O Potencial Antimicrobiano
0Original price was: $115.00.$16.00Current price is: $16.00.Niosomas: Explorar O Potencial Antimicrobiano, , 9786208332372
-
-90%
Niosomes: Explorer Le Potentiel Antimicrobien
0Original price was: $94.00.$9.00Current price is: $9.00.Niosomes: Explorer Le Potentiel Antimicrobien, , 9786208332327
-
-92%
Niosomi: Esplorazione del Potenziale Antimicrobico
0Original price was: $107.00.$9.00Current price is: $9.00.Niosomi: Esplorazione del Potenziale Antimicrobico, , 9786208332228
-
-83%

No Room for Shaky Hands: How You Can Take Your Surgical Performance to the Highest Levels
0Original price was: $105.00.$18.00Current price is: $18.00.No Room for Shaky Hands: How You Can Take Your Surgical Performance to the Highest Levels, Parashis, Andreas, 9781481819732
-
-68%

Nutritional Care of the Patient with Gastrointestinal Disease
0Original price was: $50.00.$16.00Current price is: $16.00.Nutritional Care of the Patient with Gastrointestinal Disease, Parashis, Andreas, 9781482226034
-
-77%

Opium: Its Use, Abuse and Cure;
0Original price was: $70.00.$16.00Current price is: $16.00.Opium: Its Use, Abuse and Cure;, Martin Wells Knapp, 9781018740485
-
-71%

Opium: Its Use, Abuse and Cure;
0Original price was: $45.00.$13.00Current price is: $13.00.Opium: Its Use, Abuse and Cure;, Martin Wells Knapp, 9781018745916
-
-89%

Opium: Its Use, Abuse and Cure; or, From Bondage to Freedom
0Original price was: $91.00.$10.00Current price is: $10.00.Opium: Its Use, Abuse and Cure; or, From Bondage to Freedom, Martin Wells Knapp, 9781018855578


